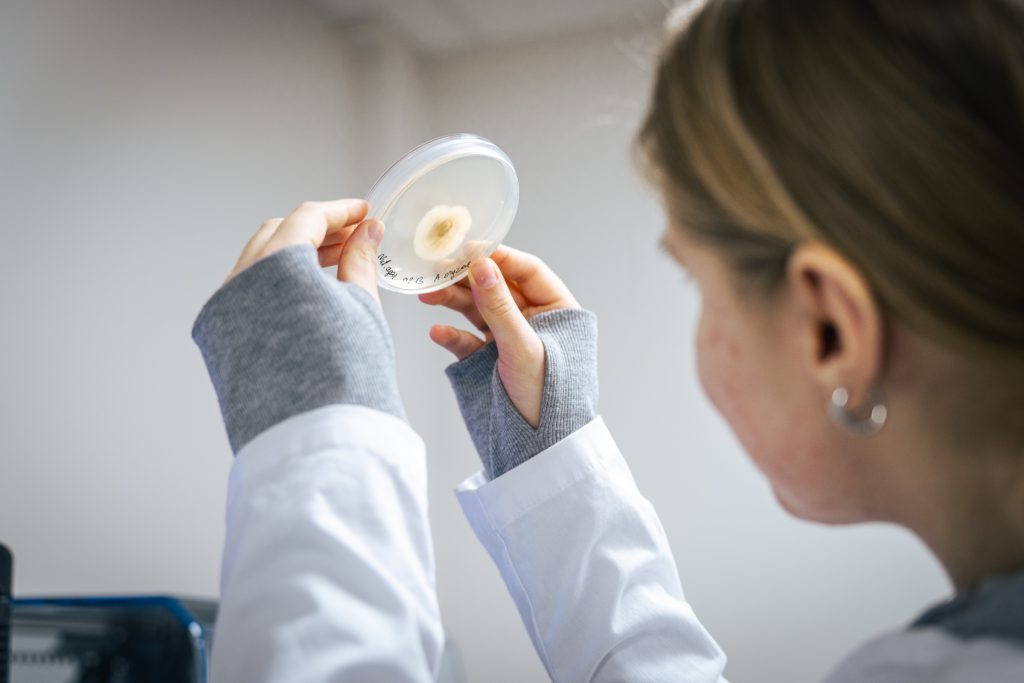

Mokslo taikomosios veiklos ir inovacijų proveržis Kauno kolegijoje: modernizuojamos laboratorijos atveria naujas galimybes
Kauno kolegija žengia dar vieną strateginį žingsnį stiprindama savo, kaip taikomųjų mokslų organizacijos, poziciją – modernizuojamos laboratorijos atveria naują etapą mokslinių taikomųjų tyrimų, inovacijų ir studijų kokybės plėtroje. Nuo kultūros vertybių tyrimų ir restauravimo iki pažangių medžiagų analizės bei mikrobiologinių inovacijų – atnaujinta infrastruktūra sukuria ekosistemą, kurioje susijungia moksliniai taikomieji tyrimai, verslas ir studijos.
Pasak Kauno kolegijos direktoriaus pavaduotojos mokslo ir organizacijos plėtrai dr. Ingos Stravinskienės, nauja ir modernia įranga aprūpintos laboratorijos ne tik sustiprins mokslinių tyrimų ir eksperimentinės plėtros (MTEP) potencialą, bet ir sudarys sąlygas vykdyti aktualius taikomuosius tyrimus, rengti konkurencingus specialistus bei plėtoti tarpdisciplininius sprendimus, atliepiančius regiono ir nacionalinius poreikius: „Džiugu tai, kad buvo parengtos mokslo infrastruktūros paraiškos Lietuvos mokslo tarybai ir daliai įrangos, esančios šiose laboratorijose, gautas finansavimas. Tai investicija į ateitį, kurioje inovacijos gimsta iš mokslo, o žinios – iš praktikos.“
Nuo kultūros paveldo išsaugojimo iki pramoninių inovacijų
Duris atvėrusi Medžiagų fizikinių ir cheminių tyrimų laboratorija bus aprūpinta naujausia įranga, kuri leis Menų ir ugdymo bei Informatikos, inžinerijos ir technologijų fakultetų tyrėjams atlikti kokybiškus taikomuosius tyrimus, plėtoti MTEP veiklą, o Baldų inžinerijos, Pramoninio dizaino inžinerijos ir Objektų konservavimo ir restauravimo studijų programų studentams – atlikti laboratorinius darbus ir įgyti praktinių tyrimų kompetencijų.
Pasak Kauno kolegijos Menų ir ugdymo fakulteto lektorės Eglės Aleknaitės, šiandien restauravimas jau peržengė tradicinio amato ribas – tai tarpdisciplininė sritis, jungianti chemiją, fiziką, medžiagotyrą, istoriją, menotyrą ir pažangias technologijas. Dėl to moderni tyrimų infrastruktūra yra būtina tiek kokybiškiems taikomiesiems tyrimams, tiek studijoms, grįstoms realia kultūros vertybių analize.
„Ši laboratorija sudarys galimybes atlikti tiek neinvazinius, tiek invazinius tyrimus – nuo medžiaginės sudėties ir technologinės sandaros analizės iki degradacijos procesų nustatymo bei restauravimo sprendimų pagrindimo. Tai reikšmingas žingsnis stiprinant Kauno kolegijos MTEP potencialą ir plečiant bendradarbiavimą su muziejais, archyvais bei bibliotekomis“, – pabrėžia Kauno kolegijos lektorė.
Atsižvelgiant į ribotą specializuotos tyrimų infrastruktūros prieinamumą Lietuvoje, ši laboratorija, pažymi E. Aleknaitė, svarbi ne tik instituciniu, bet ir regioniniu bei nacionaliniu mastu: „Ji prisidės prie nuoseklios kultūros vertybių tyrimų ir išsaugojimo sistemos plėtros.“
Tuo tarpu Informatikos, inžinerijos ir technologijų fakulteto tyrėjas doc. dr. Gintaras Keturakis atskleidžia, jog ši laboratorija suteiks galimybę atlikti įvairių medžiagų analizę – joje įdiegta bandymo mašina, klimatinė kamera, optiniai mikroskopai, rentgeno spindulių difrakcijos (XRD) ir FTIR spektroskopijos prietaisai, paviršiaus šiurkštumo matavimo įranga.
„Ši techninė bazė suteikia galimybę tirti medienos ir jos produktų, plastikų, kompozitų bei apdailos medžiagų fizikines, mechanines ir eksploatacines savybes. Laboratorijoje dirbantys tyrėjai vykdo eksperimentinius ir MTEP projektus, rengia aukšto lygio mokslines publikacijas ir prisideda prie naujų technologinių sprendimų kūrimo“, – sako doc. dr. G. Keturakis.
Inovacijos mikrobiologijoje: nuo saugaus maisto iki tvarios kosmetikos
Informatikos, inžinerijos ir technologijų fakultete duris atvėrusi moderni Tyriminė mikrobiologijos laboratorija žymi reikšmingą žingsnį stiprinant mokslo, inovacijų ir verslo bendradarbiavimą. Pasak fakulteto tyrėjos doc. dr. Jurgitos Mikašauskaitės-Tiso, atvykus visai įrangai, laboratorijoje bus II saugos lygio laminarinė spinta, bazinė mikrobiologijos įranga, fermentacijos įranga, klimatinė kamera, automatinis kolonijų skaičiuoklis, ultragarsinis homogenizatoriumas, šviesinis bei fluorescencinis mikroskopai bei UV-Vis spektrofotometras.
„Visa ši įranga sudarys sąlygas saugiai atlikti reikalingus mikrobiologinius žaliavų, maisto produktų, kosmetikos gaminių ir kitų produktų tyrimus. Laboratorija išsiskiria tarpdiscipliniškumu – atliekant tyrimus bus glaudžiai bendradarbiaujama su Kauno kolegijos Medicinos fakulteto Genetikos laboratorija, todėl atsiveria galimybės taikyti molekulinius metodus mikroorganizmų identifikavimui, mikrobiotos sudėties analizei, atsparumo genų nustatymui ar funkcinių savybių tyrimams“, – dalinasi doc. dr. J. Mikašauskaitė-Tiso.
Tai, pažymi ji, leidžia pereiti nuo tradicinės mikrobiologinės kontrolės prie išsamaus biologinių procesų supratimo ir inovatyvių sprendimų kūrimo. Kauno kolegijos tyrėja atskleidžia, kad šalia šios laboratorijos esanti atnaujinta instrumentinės analizės laboratorija su spektrofotometrinės ir chromatografinės analizės prietaisais dar labiau išplečia tyrimų spektrą.
„Integruojant mikrobiologinius ir cheminės analizės metodus galima vertinti fermentacijos procesų efektyvumą, identifikuoti bei kiekybiškai nustatyti bioaktyvius junginius, analizuoti žaliavų sudėtį, stabilumą ir biodegradaciją. Tai sudaro sąlygas vykdyti išsamius tyrimus – nuo mikroorganizmų augimo dinamikos iki galutinio produkto kokybės ir saugos pagrindimo“, – sako Kauno kolegijos docentė.
Ji priduria, kad laboratorijoje bus įgyvendinami inovatyvūs projektai, tarp jų – beatliekės technologijos principais grįsti sprendimai, kuriant tvarius bioklijų su ligninu mišinius kompozicinių medžiagų gamybai, bei fermentuotų žaliavų taikymas inovatyvių užkandžių ir kosmetologinių priemonių kūrimui.
„Šie projektai prisideda prie žiedinės ekonomikos principų įgyvendinimo, biožaliavų vertės didinimo ir aukštos pridėtinės vertės produktų kūrimo. Ši laboratorija suteikia galimybę mokslininkams vykdyti pažangius fundamentinius ir taikomuosius tyrimus, įtraukti motyvuotus ir gabius studentus į mokslinius tyrimus ir efektyviau bendradarbiauti su verslo įmonėmis“, – pažymi doc. dr. J. Mikašauskaitė-Tiso.
Kauno kolegijoje esanti moderni mokslo taikomosios bei meno veiklos infrastruktūra ir profesionali bendruomenė leidžia kokybiškai ir pažangiai vykdyti taikomąją mokslo ir meno veiklą.
Taikomoji mokslo ir meno veikla yra nukreipta į novatoriškų sprendimų formavimą ir veiksmingą jų taikymą. Kauno kolegija su suinteresuotomis šalimis sprendžia visuomenei ir aplinkai aktualias problemas bei prisideda prie regiono pažangos taikant naujausias mokslo žinias.